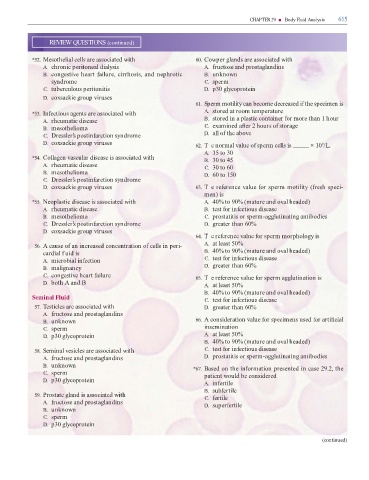

Page 631 - Clinical Hematology_ Theory _ Procedures ( PDFDrive )
P. 631
CHAPTER 29 ■ Body Fluid Analysis 615
REVIEW QUESTIONS (continued)
*52. Mesothelial cells are associated with 60. Cowper glands are associated with
A. chronic peritoneal dialysis A. ructose and prostaglandins
B. congestive heart ailure, cirrhosis, and nephrotic B. unknown
syndrome C. sperm
C. tuberculous peritonitis D. p30 glycoprotein
D. coxsackie group viruses
61. Sperm motility can become decreased i the specimen is
*53. In ectious agents are associated with A. stored at room temperature
A. rheumatic disease B. stored in a plastic container or more than 1 hour
B. mesothelioma C. examined a er 2 hours o storage
C. Dressler’s postin arction syndrome D. all o the above
D. coxsackie group viruses 62. T e normal value o sperm cells is × 10 /L.
9
A. 15 to 30
*54. Collagen vascular disease is associated with B. 30 to 45
A. rheumatic disease C. 30 to 60
B. mesothelioma D. 60 to 150
C. Dressler’s postin arction syndrome
D. coxsackie group viruses 63. Te re erence value or sperm motility ( resh speci-
men) is
*55. Neoplastic disease is associated with A. 40% to 90% (mature and oval headed)
A. rheumatic disease B. test or in ectious disease
B. mesothelioma C. prostatitis or sperm-agglutinating antibodies
C. Dressler’s postin arction syndrome D. greater than 60%
D. coxsackie group viruses
64. T e re erence value or sperm morphology is
56. A cause o an increased concentration o cells in peri- A. at least 50%
cardial f uid is B. 40% to 90% (mature and oval headed)
A. microbial in ection C. test or in ectious disease
B. malignancy D. greater than 60%
C. congestive heart ailure 65. T e re erence value or sperm agglutination is
D. both A and B A. at least 50%
B. 40% to 90% (mature and oval headed)
Seminal Fluid C. test or in ectious disease
57. esticles are associated with D. greater than 60%
A. ructose and prostaglandins
B. unknown 66. A consideration value or specimens used or arti cial
C. sperm insemination
D. p30 glycoprotein A. at least 50%
B. 40% to 90% (mature and oval headed)
58. Seminal vesicles are associated with C. test or in ectious disease
A. ructose and prostaglandins D. prostatitis or sperm-agglutinating antibodies
B. unknown *67. Based on the in ormation presented in case 29.2, the
C. sperm patient would be considered
D. p30 glycoprotein
A. in ertile
B. sub ertile
59. Prostate gland is associated with C. ertile
A. ructose and prostaglandins D. super ertile
B. unknown
C. sperm
D. p30 glycoprotein
(continued)